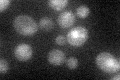
YAL015C
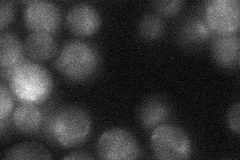
YAL015C
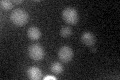
YAL015C

View description
DNA N-glycosylase and apurinic/apyrimidinic (AP) lyase involved in base excision repair; distribution between nucleus and mitochondrion varies according to which compartment is under oxidative stress and is also sumoylation-dependent
Localization:
Intensity:
Fold change:
Significance:
-
C’ GFP library in SD
nucleus20.77 -
N' NOP1pr-GFP in SD

mitochondria135.98 -
N' TEF2pr-mCherry in SD

mitochondria101.304 -
N' NATIVEpr-GFP in SD
cytosol22.9697 -
N' TEF2pr-VC and Cyto-VN in SD

#N/A0 -
C’ GFP library in SD+DTT

punctateN/AN/AYes -
C’ GFP library in SD+H2O2

nucleus18.430.88No -
C’ GFP library in Starvation Media
nucleus25.051.2No -
C’ GFP library on the background of Pup2-DaMP

N/A -
C’ GFP library on the background of CCT mutant

N/A0N/AYes
